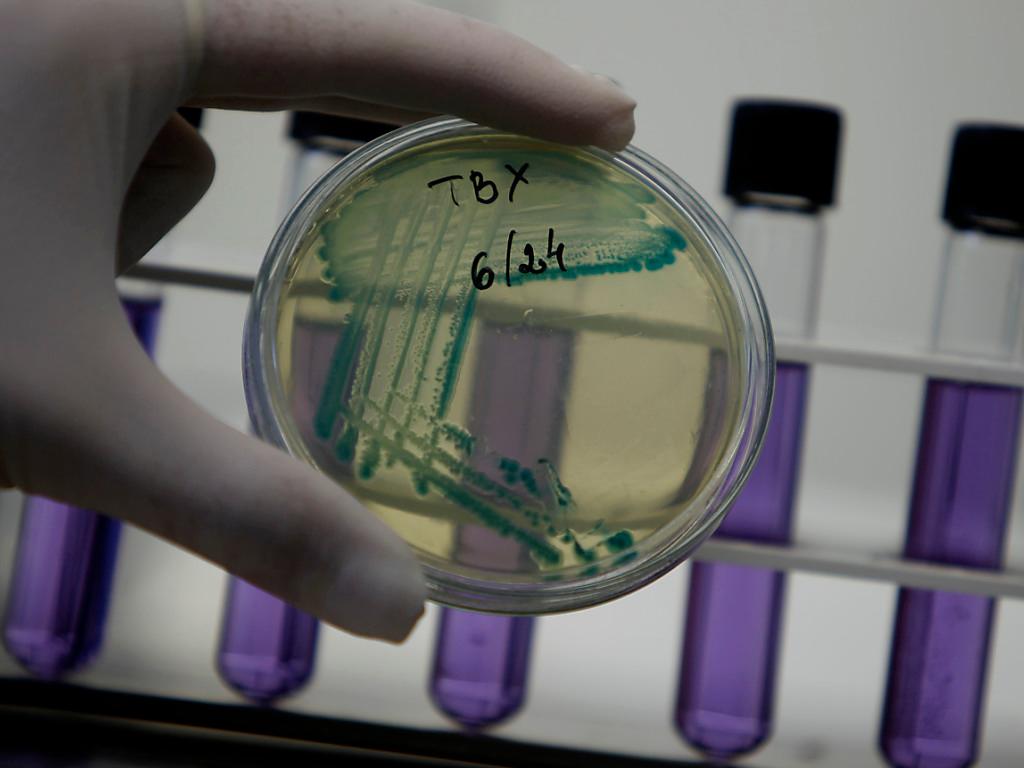

Résistance aux antibiotiques: un mort toutes les 3 secondes en 2050
(Keystone-ATS) Dix millions de personnes supplémentaires par an, soit une toutes les trois secondes, pourraient décéder à cause de la résistance aux antibiotiques à l’horizon 2050. C’est ce qu’indique le rapport final d’une grande étude britannique jeudi.
Chargé par le gouvernement britannique de ce rapport sur la résistance des antimicrobiens, l’économiste Jim O’Neill a souligné que des actions urgentes étaient nécessaires pour éviter que la médecine préventive retourne « au Moyen Age ».
« Il faut que cela devienne une priorité pour tous les chefs d’État », a souligné Jim O’Neill en proposant une batterie de mesures à mettre en oeuvre.
Son rapport appelle à un changement drastique dans la manière d’utiliser les antibiotiques, dont la surconsommation et la mauvaise utilisation favorisent la résistance des « super-bactéries ».
Sensibiliser le public
Il préconise le lancement d’une large campagne de sensibilisation du public, largement « ignorant » des risques. D’établir un fonds de recherche de 2 milliards de dollars. De réduire fortement l’utilisation des antibiotiques dans l’élevage.
Ou encore de récompenser les laboratoires qui développeraient un nouvel antibiotique à travers une prime d’un milliard de dollars. « Il faut arrêter de prendre des antibiotiques comme des bonbons », a insisté Jim O’Neill.
Un million de morts depuis mi-2014
Depuis le début du lancement, mi-2014, de l’étude, plus d’un million de personnes sont mortes à cause d’une infection liée à la résistance aux antibiotiques, souligne le rapport.
Il estime que ce bilan pourrait s’alourdir de quelque 10 millions de décès supplémentaires par an d’ici 2050, soit plus que le cancer aujourd’hui, et coûter jusqu’à 100’000 milliards de dollars à l’économie mondiale.
L’efficacité déclinante des antibiotiques inquiète fortement la communauté scientifique. L’Organisation mondiale de la santé (OMS) a averti en novembre que le phénomène représentait « un immense danger » et que, si rien n’était fait, la planète se dirigeait vers une « ère post-antibiotique, dans lequel les infections courantes pourront recommencer à tuer ».
La résistance aux antibiotiques, également appelée l’antibiorésistance, survient lorsqu’une bactérie évolue et devient résistante aux antibiotiques utilisés pour traiter les infections.